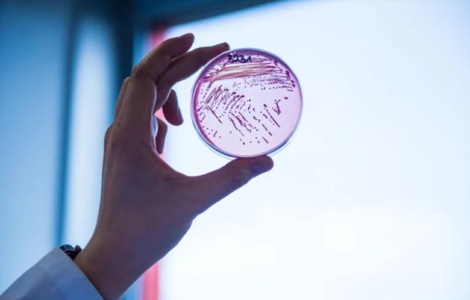

En los últimos tres años hubo un aumento confirmado de casos de personas con el Síndrome Urémico Hemolítico (SUH) en la Argentina, según el Ministerio de Salud de la Nación. Los casos habían estado en descenso desde 2014 hasta 2021 pero desde ese año, la cartera sanitaria verificó un “ligero aumento”, que pasa de una tasa de 0.30 por cada 100.000 habitantes a una de 0.34, según los informó en su último Boletín Epidemiológico. Esto significa un 13,33% de incremento de casos.
El Síndrome Urémico Hemolítico (SUH) es una enfermedad grave, caracterizada por daño agudo de los riñones, asociado a alteraciones en las células de la sangre: trombocitopenia (reducción de plaquetas, necesarias para formar los coágulos) y anemia (causada por ruptura anormal de glóbulos rojos). Afecta a niños y niñas menores de cinco años principalmente, pero también a embarazadas, adultos mayores y personas con su sistema inmunológico debilitado.
Según la Organización Mundial de la Salud (OMS), Argentina tiene una de las tasas de incidencia más altas del mundo de SUH. Es la primera causa en nuestro país de insuficiencia renal aguda en lactantes y niñas y niños pequeños, y la segunda causa de enfermedad renal crónica, de acuerdo al Comité Nacional de Nefrología de la Sociedad Argentina de Pediatría. De esta manera, es responsable de aproximadamente el 20% de los trasplantes renales en niñas, niños y adolescentes.
En Argentina, el Síndrome Urémico Hemolítico es una enfermedad endémica. Se transmite por ingestión de alimentos o aguas contaminadas, de persona a persona y por contacto con el medio ambiente, ya que la bacteria puede sobrevivir meses en el estiércol. El contacto directo con animales debe ser con precaución y hay que tener en cuenta circunstancias como las visitas a granjas, frecuentes en edad preescolar y escolar.
La bacteria puede encontrarse en la carne, en frutas y verduras sin sanitizar, en la leche o lácteos sin pasteurizar e incluso en el agua, si no es potable. “En nuestro país la recomendación de no ofrecer carne picada a niños y niñas menores de 5 años, porque es uno de los productos de mayor riesgo, ya que durante el picado, la bacteria pasa de la superficie de la carne al interior del producto, donde es más difícil que alcance la temperatura necesaria para eliminarla durante la cocción”, sostuvo Erika Noelia Skrypnik, licenciada en Nutrición (MP 5259), matriculada en el Colegio de Nutricionistas bonaerense.
Asimismo, Skrypnik aseguró que “como nutricionistas debemos brindar a la población medidas para prevenir el SUH, haciendo hincapié en las infancias y sus cuidadores, entendiendo qué la prevención va más allá de la alimentación. Es importante también contar con políticas públicas qué regulen y colaboren en evitar la contaminación del ganado, tambos, y proveer agua segura para disminuir el riesgo de transmisión”.
No hay tratamiento específico para esta enfermedad, pero sí puede prevenirse, por ello el Colegio de Nutricionistas de la Provincia de Buenos Aires recomienda:
▪ Evitar que los alimentos pierdan la cadena de frío, adquirir lácteos y carnes al final de la compra.
▪ Guardar las carnes en los estantes inferiores y evitar que sus jugos se derramen en otros alimentos.
▪ Separar los alimentos crudos y cocidos en recipientes diferentes para evitar la contaminación cruzada.
▪ Evitar descongelar las carnes bajo el chorro de agua caliente o en la mesada para prevenir la contaminación. Se sugiere descongelar en la heladera.
▪ Realizar un correcto lavado de manos, previo a la manipulación de alimentos.
▪ Lavar adecuadamente frutas y verduras; si no hay agua potable colocar dos gotas de lavandina por litro de agua y dejar reposar 20 minutos.
▪ Utilizar tablas y cuchillos diferentes para alimentos crudos y cocidos y cocinar a temperatura mayor a 71 °C.
▪ Fomentar el lavado frecuente de las manos luego del cambio de pañales, uso de sanitarios y antes de preparar o ingerir alimentos.

 Mundo Profesional
Mundo Profesional